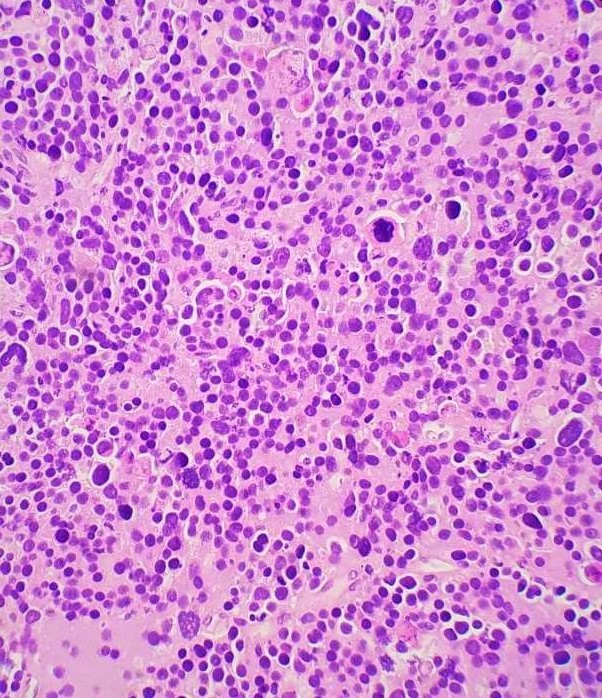

Case History
A 35-year-old male presents with scrotal pain and a 1-cm testis mass is identified on ultrasound. A frozen section is performed. What is the diagnosis?
- Leydig Cell Tumor
- Seminoma
- Embryonal Carcinoma
- Spermatocytic Tumor
Answer: “D.” Spermatocytic Tumor
Brief explanation of the answer:
Spermatocytic tumor is a rare germ cell tumor (1-2%) with an average patient age of 55 but does occur in younger individuals such as in this case. Patients often present with testicular swelling with mass. Serum tumor markers are generally not elevated. Macroscopically, these tumors appear as a well-circumscribed tan-grey mass with a bulging surface. Microscopically, these tumors demonstrate a diffuse or sheet-like pattern with edematous stroma and separation by fibrous bands. The tumor is comprised of a polymorphous cell population comprised of 3 main cell types: Small lymphocyte-like cells, intermediate cells and giant cells. Germ cell neoplasia is usually not associated with spermatocytic tumors. The tumor cells are positive for SALL4, CD117, OCT2, CAM 5.2 (40%), and negative for CD30, PLAP, AFP, OCT3/4, D2-40, Glypican-3, EMA, CD30 and Vimentin. The differential diagnosis includes seminoma, embryonal carcinoma (solid pattern) and malignant lymphoma. Radical inguinal orchiectomy is curative with an excellent prognosis.
Case contributed by: Scott Taylor, D.O., Fellow, Surgical Pathology